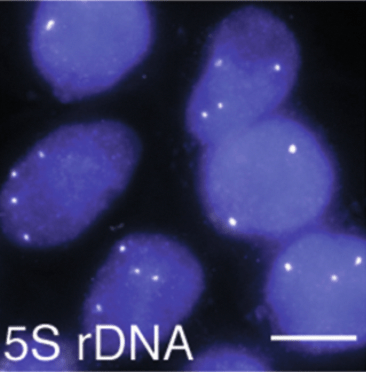

Multimodal profiling reveals cell type-specific pseudouridine modification and density-dependent translational regulation
Caroline A. McCormick, Michele Meseonznik, Yuchen Qiu, Oleksandra Fanari, Priyanka Goyal, Mitchell Thomas, Mina Shokoufandeh, Yifang Liu, Dylan Bloch, Cole Greenfield, Isabel N Klink, Miten Jain, Meni Wanunu & Sara H Rouhanifard
Nucleic Acids Research. April 2026.

Multi-Scale Kinetics Modeling and Advanced Assay for mRNA-Lipid Nanoparticle Potency Assessment
Yuling Yang, Yuchen Qiu, Keqi Wang, Yifang Liu, Gautam Sanyal, Paul C. Whitford, Sara H. Rouhanifard & Wei Xie
bioRxiv, Oct 2025.

Pore-Based RNA Evaluation for Control of Integrity, Sequence, and Errors-Quality Control (PRECISE-QC)
Yvonne Yee, Dinara Boyko, Bhoomika Pandit, Maksim Royzen, Meni Wanunu & Sara H. Rouhanifard.
bioRxiv, Sept 2025.

Protocol for differential analysis of pseudouridine modifications using nanopore DRS and unmodified transcriptome control
Oleksandra Fanari, Michele Meseonznik, Dylan Bloch & Sara H. Rouhanifard.
STAR Protocols, Aug 2025.

Oleksandra Fanari, Dylan Bloch, Yuchen Qiu, Michele Meseonznik, Dinara Boyko, Amr Makhamreh, Meni Wanunu & Sara H. Rouhanifard.
RNA, July 2025.

NuclampFISH enables cell sorting based on nuclear RNA expression for chromatin analysis
Yifang Liu, Yuchen Qiu, Keqing Nian & Sara H. Rouhanifard.
BMC Genomics, July 2025.

Keqing Nian, Yifang Liu, Yuchen Qiu, Zhuoyu Zhang, Laura Brigandi, Meni Wanunu & Sara H. Rouhanifard.
Nature Communications, May 2025.

Probing enzyme-dependent pseudouridylation using direct RNA sequencing to assess epitranscriptome plasticity in a neuronal cell line
Oleksandra Fanari, Sepideh Tavakoli, Yuchen Qiu, Amr Makhamreh, Keqing Nian, Stuart Akeson, Michele Meseonznik, Caroline A McCormick, Dylan Bloch, Howard Gamper, Miten Jain, Ya-Ming Hou, Meni Wanunu, Sara H Rouhanifard.
Cell Systems, March 2025.

Nanopore signal deviations from pseudouridine modifications in RNA are sequence-specific: quantification requires dedicated synthetic controls
Makhamreh A, Tavakoli S, Fallahi A, Kang X, Gamper H, Nabizadehmashhadtoroghi M, Jain M, Hou YM, Rouhanifard SH*, Wanunu M*.
Scientific Reports, September 2024

Multicellular, IVT-derived, unmodified human transcriptome for nanopore-direct RNA analysis.
Caroline A McCormick*, Stuart Akeson*, Sepideh Tavakoli, Dylan Bloch, Isabel N. Klink, Miten Jain*, Sara H. Rouhanifard*.
Gigabyte. June 2024.

Paired Capture and FISH Detection of Individual Virions Enable Cell-Free Determination of Infectious Titers.
Yifang Liu, Jacob L. Potts, Dylan Bloch, Keqing Nian, Caroline A. McCormick, Oleksandra Fanari and Sara H Rouhanifard.
ACS Sensors 2023 Jun 27.

Enzymatic synthesis of RNA standards for mapping and quantifying RNA modifications in sequencing analysis.
Gamper H, McCormick CA, Tavakoli S, Wanunu M, Rouhanifard SH, Hou YM.
Methods in Enzymology. 2023 May 15.

Semi-quantitative detection of pseudouridine modifications and type I/II hypermodifications in human mRNAs using direct long-read sequencing
Sepideh Tavakoli, Mohammad Nabizadeh, Amr Makhamreh, Howard Gamper, Caroline A McCormick, Neda K Rezapour, Ya-Ming Hou, Meni Wanunu, Sara H Rouhanifard.
Nature Communications 2023 Jan 19.

clampFISH 2.0 enables rapid, scalable amplified RNA detection in situ
Dardani I, Emert BL, Goyal Y, Jiang C, Kaur A, Lee J, Rouhanifard SH, Alicea GM, Fane EM, Xiao M, Herlyn M, Weeraratna AT, Raj A.
Nature Methods. 2022 Oct 24.
Click chemistry-based amplification and detection of endogenous RNA and DNA molecules in situ using clampFISH probes
Tavakoli S, Liu Y, Potts JL, Rouhanifard SH.
Methods in Enzymology. 2020 Jan 1.

ClampFISH detects individual nucleic acid molecules using click chemistry–based amplification
Rouhanifard SH, Mellis IA, Dunagin M, Bayatpour S, Jiang CL, Dardani I, Symmons O, Emert B, Torre E, Cote A, Sullivan A, Stamatoyannopoulos JA, Raj A.
Nature Biotechnology. 2019 Jan 1.



Neutrophils and Ly6Chi monocytes collaborate in generating an optimal cytokine response that protects against pulmonary Legionella pneumophila infection.
Cierra N Casson, Jessica L Doerner, Alan M Copenhaver, Jasmine Ramirez, Alicia M Holmgren, Mark A Boyer, Ingharan J Siddarthan, Sara H Rouhanifard, Arjun Raj, Sunny Shin.
PLoS Pathogens. 2017 Apr 6.



